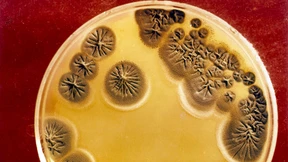
Umschwärmt von Mikroben

Eisbergmusik für alle
Es gibt so gut wie nichts, was es nicht gibt im Netz der Netze: Geniales, Interessantes, Nützliches und herrlich Überflüssiges. Diesmal: Klagelieder des schmelzenden Eises.

Es gibt so gut wie nichts, was es nicht gibt im Netz der Netze: Geniales, Interessantes, Nützliches und herrlich Überflüssiges. Diesmal: Klagelieder des schmelzenden Eises.

Viagra-Produzent Pfizer fusioniert mit der Firma Allergan. Deren Bestseller Botox ist vor allem als Mittel zur Hautstraffung und Faltenminderung. Doch was kann er noch?

Wie funktioniert ein Sommerhit? Und warum können wir auch das schönste Weihnachtslied irgendwann nicht mehr ertragen? Antworten sucht die empirische Ästhetik.

Alarmistische Bußpredigten von Klimaforschern will keiner mehr hören. Was wir jetzt brauchen, das sind keine Maximalforderungen zur Abwendung der Erderwärmung sondern eine realistische Politik der kleinen Schritte.

Was macht eigentlich die Apokalypse so kurz vor dem Weltklimagipfel? Unser Glossenticker mit ernsten Nachrichten zum Klimawandel und ihren (weniger ernsten) Pointen. Ein Update zu kurzlebigen Schadstoffen im ewigen Eis, zu Unwetteropfern und zur Auferstehung einer Ökogroßmacht.

Ein Brief Einsteins ist aufgetaucht: Anders als behauptet, hat der Vater der Relativitätstheorie seine alte Heimat 1952 noch einmal besucht. Warum aber ausgerechnet Büdingen?

Vor hundert Jahren formulierte Albert Einstein seine berühmten Feldgleichungen der Gravitation und vollendete damit sein zweites Lebenswerk: die Allgemeine Relativitätstheorie. Wie kam es dazu?

Empörung, Scham, Ohnmachtsgefühle – ein ganzes Bündel von Motiven kann zu Terrorismus führen. Aber es gibt auch einen Weg zurück.

Ist das Allerwelts-Pestizid jetzt krebserregend oder nicht? Die Experten stiften Chaos, aber wehe wir suchen im Biomarkt nach Antworten.

Bei manchen Blutdruckpatienten helfen keine Pillen. Gezielte Stromstöße könnten eine Alternative sein. An der komplizierten Technik muss allerdings noch kräftig gefeilt werden.

Rein rechnerisch kommen auf jeden Erdenbewohner mehr als vierhundert Bäume. Doch das ist nur auf den ersten Blick eine gute Nachricht.

Nur die wenigsten Meteorologen beschäftigen sich überhaupt mit der Wettervorhersage. Die aber, die es tun, brauchen heutzutage Showqualitäten.

Der Bundesfinanzminister hat bemerkt, dass ein Skifahrer eine Lawine auslösen kann. Wie darf man das verstehen?

Alle Menschen seien gleich, heißt es. Aber niemand glaubt das wirklich. Schon von Herkunft sind wir verschieden. Kann man deshalb von menschlichen Rassen reden?

Für den Klimagipfel von Paris putzen sich die Staaten ökologisch heraus. Plötzlich sind alle Umweltriesen. Ein „Laborbesuch“ mit der Probe aufs Exempel.

Die Luftqualität in den Ländern Südostasiens leidet immer mehr, angefacht durch klimabedingte Dürren und Waldbrände. Wie ein Kommentar aus Singapur zeigt, wächst die Ungeduld mit den trägen Regierungen.

Ganz nah und doch noch ziemlich fern: Astronomen haben einen Exoplaneten entdeckt, der ihnen endlich mehr liefern könnte als nur verschwommene Umrisse.

Die Evolution führt im Tierreich manchmal zu überraschend ähnlichen Ergebnissen, wie die bewährte Abwehrstrategie gegen das tückische Gift der Kröten zeigt.

Der Klimagipfel in Paris steht vor einer Chance, die oft vergessen wird: Indigene Völker können und wollen Verantwortung für die Urwälder übernehmen. Ein Gastbeitrag.
Die schlechte Nachricht lautet: Jetzt kommt die trübe Jahreszeit. Und die gute? Nebel wird immer seltener.

Können andere Lebewesen Krebsgeschwüre auf Menschen übertragen? In Kolumbien haben Ärzte bei einem Patienten Tumorzellen eines Bandwurms entdeckt. Offen ist nur noch, ob der Parasit auch selbst Krebs hatte.
Eulen beflügeln unsere Phantasie, weil man sie fast nie zu Gesicht bekommt. Und wenn doch, staunen wir umso mehr.

Sie sind um die 40, kinderlos und schieben die Familiengründung immer weiter hinaus: Die Wissenschaft entdeckt eine Frauengeneration, die auf „Social Freezing“ und Samenspenden vertraut – oftmals allzu blauäugig.

Psychische Störungen und Armut betreffen Menschen oft gleichzeitig. Schwedische Forscher zeigen jetzt, dass psychisch kranke Probanden weniger Symptome zeigen, wenn man ihnen monatlich einen kleinen Geldbetrag zusätzlich überlässt.

Wie „grün“ ist Vorreiter Deutschland beim Klimaschutz wirklich, fragt die führende belgische Tageszeitung? Ihr Blick richtet sich auf die Energiewende. Und da findet man manches „Paradoxe“.

Wie kann es sein, dass Schinken und Salami plötzlich Krebs auslösen?

Die Saturnsonde „Cassini“ taucht ab: So tief wie nie zuvor ist „Cassini“ in die Wolken aus Eisteilchen und Wasserdampf des Saturnmonds Enceladus eingedrungen.

So nah wie an diesem Mittwochnachmittag ist „Cassini“ noch niemals zuvor am Saturnmond Enceladus vorübergerauscht. Der Abstand der amerikanischen Raumsonde zur Oberfläche des Trabanten betrug nur 50 Kilometer. Bei dem Manöver flog sie auch durch die Eisfontänen auf dem Südpol. Auf die aktuellen Bilder darf man also gespannt sein.

Schmerzen entstehen nicht im Gehirn, aber ohne unser Hirn wären sie nicht existent. Mehr noch: Das Gehirn ist der große Schmerzmanipulator. Aber sobald wir das Gehirn und seine Netzwerke besser kennen, können wir Schmerzen auch gezielt ausschalten.

Es gibt so gut wie nichts, was es nicht gibt im Netz der Netze: Geniales, Interessantes, Nützliches und herrlich Überflüssiges. Diesmal: Checklisten für alle Lebenslagen.
Sie kennen weder Angst noch Rache: Roboter wären effiziente Soldaten. Für viele Forscher ist das eine Horrorvorstellung. Aber nicht für alle.

Man nehme Bazillen, Papier und Dampf. Daraus zaubert die „Moisture Mill“ einen Antrieb für Motoren. Sie nutzt die Verdunstung von Wasser zur Stromerzeugung.
Jeder Mensch ist von einer individuellen Wolke aus Bakterien umgeben. Das kann bei der Aufklärung von Verbrechen von großem Nutzen sein.

Die Vorbereitungen für die Reise zum roten Planeten laufen auf Hochtouren. Freiwillige warten sehnsüchtig auf das Startsignal. Sogar der Vatikan hat bereits einen hoffnungsvollen Blick in Richtung Mars.

Brustkrebspatientinnen sollten am besten selbst zu Expertinnen werden: Implantat oder Eigengewebe, einseitig oder gleich beide? Wichtig ist vor allem ein gutes Brustzentrum. Und überstürzt sollte nichts entschieden werden.

Kohlenhydrate zählen wie die Gene zu den elementaren Bausteinen des Lebens. In Berlin geht man dem Alphabet der Zuckermoleküle im Windkanal auf die Spur.